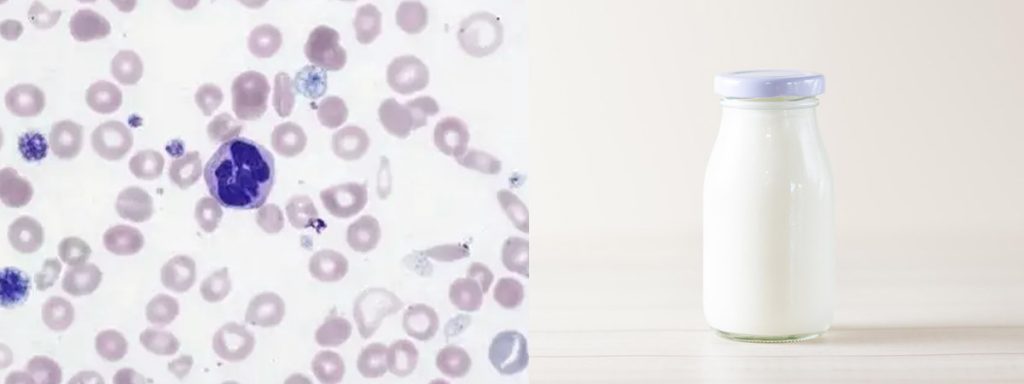
what-does-somatic-cell-count-measure

Cheesemakers pay close attention to somatic cell counts in milk because even a slight increase can harm milk’s overall quality. Somatic cells come from the cow’s immune system and signal udder health. High-quality milk relies on low levels of these cells. Regular use of a somatic cell count tester helps producers catch problems early and maintain strict quality control. Dairies that monitor closely see better cheese texture, flavor, and yield.
Key Takeaways
- Somatic cell counts in milk indicate udder health. Low counts mean healthier cows and better milk quality.
- Regular monitoring of somatic cell counts helps cheesemakers improve cheese texture, flavor, and yield.
- High somatic cell counts can lead to off-flavors and lower cheese quality. Keeping counts low is essential for great cheese.
- Good management practices, like clean bedding and prompt mastitis treatment, help maintain low somatic cell counts.
- Using a somatic cell count tester allows for quick checks on milk quality, ensuring consistent production and compliance.
Somatic Cell Counts in Milk and Cheese Quality
What Are Somatic Cells?
Somatic cells mainly consist of leukocytes, with neutrophils as the most common type. These cells serve as part of the cow’s immune system, protecting the mammary gland from infections. When a cow faces an infection, such as mastitis, the number of somatic cells in milk rises sharply. Neutrophils, lymphocytes, and macrophages each play a role in defending the udder. Neutrophils respond quickly to infection, while lymphocytes regulate immune responses and macrophages remove bacteria and debris. In healthy cows, macrophages and lymphocytes dominate. When infection occurs, neutrophils increase, signaling a problem that can affect both milk production and quality.
Link to Udder Health
Somatic cell counts in milk act as a reliable indicator of udder health. High counts often point to intramammary infections, which can compromise both the cow’s well-being and the milk’s suitability for cheese making. The following table shows how different somatic cell count levels relate to udder health and milk quality in various regions:
| Somatic Cell Count (SCC) | Udder Health Status | Milk Quality Status |
|---|---|---|
| > 2 × 10^5 cells/mL | Infected | Not specified |
| > 4 × 10^5 cells/mL | Infected | Unfit for human consumption (EU) |
| 1 × 10^5 cells/mL (Germany) | Acceptable | Acceptable |
| 5 × 10^5 cells/mL (Canada) | Acceptable | Acceptable |
| 7.5 × 10^5 cells/mL (USA) | Acceptable | Acceptable |
Somatic cell counts in milk reflect the immune status of the mammary gland. When the count stays low, cows remain healthy, and milk production continues at optimal levels. High counts signal infection, which can reduce both the quantity and quality of milk.
Effects on Cheese Flavor and Texture
Cheesemakers monitor somatic cell counts in milk because high levels can harm cheese quality in several ways:
- Cheeses made from high somatic cell count milk often receive lower total sensory scores.
- Body and texture scores drop compared to cheeses made from low or medium count milk.
- Texture changes may include increased hardness and altered springiness.
| Change in Cheese Characteristics | Description |
|---|---|
| Flavor | Development of off-flavors due to increased proteolytic and lipolytic activity. |
| Texture | Alterations in texture, affecting body and sensory characteristics. |
- Higher somatic cell counts in milk are linked to lower cheese yield and quality.
- Milk with counts at or below 200,000 cells per mL produces higher cheese yields.
- While reducing somatic cell counts does not always affect fresh cheese yield, it can influence the sensory qualities and overall quality of dairy products.
High somatic cell counts also impact the composition of milk, reducing important components like fat, protein, and casein. These changes can lower cheese yield and affect the recovery of nutrients in the curd. The ability of milk to coagulate, which is essential for cheese making, may also decline. Over time, cheeses made from high count milk may develop sensory defects such as rancidity and bitterness, especially during aging and storage. Increased lipolysis and proteolysis can speed up degradation, shortening shelf life and reducing product quality.
Tip: Regularly monitoring somatic cell counts in milk helps cheesemakers maintain high cheese quality, improve yield, and ensure a consistent product for consumers.
Causes of High Somatic Cell Counts
Mastitis and Infections
Mastitis stands as the leading cause of high somatic cell counts in dairy herds. Clinical mastitis, which shows visible symptoms, and subclinical mastitis, which often goes unnoticed, both increase the number of immune cells in milk. When a cow develops acute mastitis, inflammation in the mammary gland triggers the body to send more immune cells to fight infection. This process raises somatic cell levels. The most common culprits include contagious pathogens such as Staphylococcus aureus, Streptococcus agalactiae, and Streptococcus dysgalactiae, which spread from cow to cow. Environmental pathogens like Streptococcus uberis, Enterococcus species, and coliform bacteria also contribute to udder infections during milking. Infections with Streptococcus uberis, Escherichia coli, and Staphylococcus aureus can push somatic cell counts above 200,000 cells per milliliter. Minor pathogens, such as Corynebacterium species and coagulase-negative Staphylococci, usually result in lower counts but still affect milk quality.
Clinical mastitis causes inflammation, alters vascular permeability, and damages the cells that produce milk. These changes lead to higher somatic cell counts and reduced milk production.
Environmental Factors
Environmental conditions play a significant role in somatic cell levels. Dirty bedding, poor ventilation, and contaminated water sources expose cows to harmful bacteria. Seasonal changes also impact somatic cell counts. For example, summer brings higher temperatures and humidity, which can stress cows and increase the risk of infection. The following table shows how seasonal changes affect somatic cell counts:
| Season | Median SCC (cells/mL) |
|---|---|
| Indoor Spring | 470,000 |
| Pasture Season | 1,100,000 |
| Indoor Fall | 940,000 |
Winter usually shows the lowest somatic cell counts, while summer often sees elevated levels. These fluctuations highlight the importance of maintaining a healthy udder throughout the year.
Animal Stress and Management

Stress from overcrowding, poor nutrition, or extreme weather can weaken a cow’s immune system. When cows experience heat stress, especially when the temperature-humidity index (THI) exceeds 78, somatic cell counts rise and milk production drops. The impact can last for over a week, affecting both protein and fat content in the milk. Proper management practices help prevent subclinical mastitis and clinical mastitis. Farmers who use regular cleaning routines, monitor individual cows, and separate infected animals see better results. Good nutrition, including adequate zinc, vitamin E, and selenium, supports immune function and helps maintain a healthy udder.
Effective mastitis control programs, regular cleaning, and careful monitoring of cows are essential for reducing somatic cell counts and improving milk production.
Importance of Monitoring Somatic Cell Counts
Cheesemakers recognize the importance of monitoring somatic cell counts for both milk quality and cheese production. Regular checks help maintain a healthy udder and prevent issues that can harm milk production. High somatic cell counts can lead to lower cheese yields, off-flavors, and reduced shelf life. Ongoing monitoring also protects against financial losses and ensures compliance with legal standards for milk quality.
Regular Testing Methods
Dairy producers use several methods to test somatic cell counts. The california mastitis test stands out as a quick, on-farm option for detecting high cell levels. Other common methods include the Wisconsin Mastitis Test and the Porta SCC Milk Test. For more advanced analysis, laboratories use Coulter Counters, Fossomatic Systems, and Bentley Somacount Systems. The table below summarizes these methods:
| Method | Description | Advantages/Limitations |
|---|---|---|
| California Mastitis Test | Chemical reaction for rapid on-farm SCC evaluation | Simple, cost-effective, immediate results |
| Wisconsin Mastitis Test | Variation of CMT for dairy quality testing | Quick, slightly more complex than CMT |
| Porta SCC Milk Test | Dye reaction with digital reader | Fast, cost-effective, suitable for on-farm use |
| DeLaval Cell Counter | Portable optical device for SCC detection | Fast, efficient, requires specific reagents |
| Coulter Counter | Electric counting of formalin-fixed cells | Accurate, rapid, expensive for routine farm use |
Routine testing helps identify problems early, allowing for prompt action to protect milk production and cheese quality.
Using a Somatic Cell Count Tester
A somatic cell count tester provides a practical solution for regular monitoring on the farm. This device allows producers to check milk samples quickly and identify cows with elevated cell counts. While laboratory tests offer high accuracy, repeated use of a somatic cell count tester improves reliability and serves as an effective screening tool. Early detection of high counts helps isolate affected cows, reduce disease spread, and maintain consistent milk production. The california mastitis test, when used alongside a somatic cell count tester, gives producers a comprehensive view of udder health.
“High somatic cell counts can result in lower cheese yields and problems with moisture control, making regular monitoring essential for cheesemakers.”
Best Practices for Prevention
Preventing high somatic cell counts starts with good management. Farmers should keep bedding clean and comfortable, sanitize milking equipment, and prepare cows properly before milking. Understanding udder health basics and treating mastitis cases promptly also play key roles. Farms that clean udders only when dirty and keep cows in larger groups often see lower cell counts. Effective treatment of mastitis and proper housing during dry periods further support healthy herds. These steps protect milk production and help maintain the importance of monitoring somatic cell counts for cheese quality.
- Keep bedding dry and clean
- Sanitize all milking equipment
- Prepare cows carefully before milking
- Treat mastitis cases quickly
- Provide proper housing and nutrition
Regular monitoring and prevention strategies ensure high-quality milk, better cheese, and a healthy udder for every cow.
Conclusion

Cheesemakers rely on somatic cell count monitoring to protect cheese quality. A dashboard for milk reception quality, real-time metrics, and historical trends help track changes. Studies show that high somatic cell counts reduce milk coagulation and curd firmness, which affects cheese texture. Regular testing includes microbiological checks, somatic cell count tests, and careful milk acceptance. By prioritizing udder health and consistent milk testing, producers achieve better cheese yield and flavor.
| Component | Description |
|---|---|
| Dashboard for Milk Reception Quality | Essential for assessing raw milk quality upon reception, influencing subsequent processing steps. |
| Real-time Quality Metrics | Provides current metrics against ideal values, aiding in immediate quality assessment. |
| Historical Data and Predictive Trends | Allows tracking of quality over time, helping to anticipate and manage deviations effectively. |
- Monitoring raw and pasteurized milk’s microbiological quality
- Conducting microbiological tests to assess microbial load
- Performing somatic cell count tests to guide milk acceptance for cheese production
FAQ
What Is Considered a High Somatic Cell Count in Milk?
A somatic cell count above 200,000 cells per milliliter signals a problem. Many regions set legal limits between 400,000 and 750,000 cells per milliliter. Lower counts indicate healthier cows and better milk for cheese.
How Do Somatic Cell Counts Affect Cheese Yield?
High somatic cell counts reduce cheese yield. Milk loses protein and casein, which are essential for curd formation. Cheesemakers see lower recovery rates and less product from the same amount of milk.
Can Farmers Lower Somatic Cell Counts Quickly?
Farmers can lower somatic cell counts by treating mastitis, improving cow comfort, and maintaining clean environments. Regular monitoring helps identify issues early.
Tip: Quick action prevents long-term damage to milk quality.
Why Do Cheesemakers Test Somatic Cell Counts so Often?
Cheesemakers test somatic cell counts often to catch problems early. Frequent testing ensures consistent milk quality and helps prevent defects in cheese flavor and texture.
What Tools Help Monitor Somatic Cell Counts?
| Tool Name | Usefulness |
|---|---|
| Somatic Cell Count Tester | Fast, on-farm screening |
| California Mastitis Test | Quick detection of infection |
| Laboratory Analyzers | Accurate, detailed results |